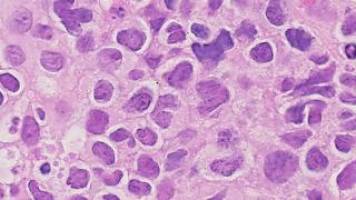
IOR lays the foundation for a new clinical trial against lymphomas

news
University of Italian Switzerland
Results 61 - 80 of 81.
Career - 11.05.2020

After lengthy negotiations conducted by swissuniversities , an agreement was reached with the publisher Elsevier to allow researchers at Swiss universities to publish free Open Access (OA) articles in the world's leading medical and scientific journals. This agreement, which covers also the University libraries of USI, applies to all Elsevier journals, including Gold OA, but excluding The Cell Press, The Lancet e several society journals .
Architecture & Buildings - Health - 04.05.2020
Epidiemology and urban planning: the views of Sascha Roesler on the NZZ
What is the relationship between epidiemology and urban planning? Sascha Roesler, assistant professor at the USI Academy of Achitecture (Institute for the History and Theory of Art and Architecture, ISA), explores the subject in a recently published article in the Neue Zürcher Zeitung and with a short video, showing how these two concepts have a common history and future.
Health - Pharmacology - 20.04.2020

An international group of researchers, led by the Institute of Oncology Research (IOR, affiliated to USI), has discovered a mechanism to recognise the cancer cells responsible for prostate cancer and selectively eliminate them. The study was published on April 6 by the Journal of Clinical Investigation (JCI).
Life Sciences - Computer Science - 10.04.2020

Traditional methods for predicting interactions between proteins and other molecules rely on complex supercomputer simulations. Instead, a group of researchers from EPFL and USI developed a new artificial intelligence system that analyzes the 3D structure of protein surfaces. The new method MaSIF (Molecular Surface Interaction Fingerprinting) is a collaboration between the EPFL Protein Design & Immunoengineering lab (headed by Prof. Bruno Correia) and the group of Michael Bronstein , professor at USI and Imperial College of London, and head of research in Graph Learning at Twitter.
Philosophy - Computer Science - 05.04.2020
Ethical challenges in the age of digitisation
The Neue Zürcher Zeitung recently published a paper on the ethical challenges of digitisation written by Peter Seele, economist, philosopher and professor of business ethics at USI Faculty of Communication, Culture and Society and Dirk Helbing, professor of Computational Social Science at ETH Zurich.
Media - Health - 30.03.2020
Four keywords to understand journalism during a pandemic
From newspapers to television, from the internet to social media, we experience an overload of information on the Covid-19 pandemic. Science journalism has become an important source to help individuals understand what is true and what is false. In this video Philip Di Salvo, a post-doc researcher at USI Institute of Media and Journalism, proposes four key words to comprehend what is happening to the media.
Pharmacology - Health - 23.03.2020
A study conducted by med. Francesco Bertoni at the Institute of Oncology Research ( IOR , affiliated to USI) has shown that a specific combination of drugs is a potentially winning strategy in the fight against lymphomas. The results obtained in the laboratory have enabled the researchers at the Istituto Oncologico della Svizzera italiana ( IOSI ) to develop a clinical study together with the Swiss Group for Clinical Cancer Research ( SAKK ).
Health - 17.03.2020

A group of researchers from the Institute for Research in Biomedicine in Bellinzona (IRB, affiliated to USI) and the European Institute of Oncology (IEO) in Milan have identified a molecular mechanism that maintains the regulation of the response of our immune system avoiding excessive responses that can damage the body.
Life Sciences - Health - 27.11.2019
IRB investigates the disposal mechanisms of damaged proteins
Causal Effects of Brevity on Style and Success in Social Media Faculty of Informatics Open lecture of the course Argumentation in Conflict Resolution Visiting Alumni: Loredana Padurean, Associate Dean, Asia School of Business «Quel ramo del lago di Como. Lettura dei «Promessi Sposi» Faculty of Communication Sciences Visiting Alumni: Elia Frapolli, Freelance Consultant Course schedules Academic calendar Humans cells select, through the endoplasmic reticulum, the damaged proteins that must be destroyed quickly to avoid their accumulation, which is toxic to our organism.
Life Sciences - Health - 31.10.2019
With a new Artificial Intelligence method, humans and machines can analyse complex biomedical data
An interdisciplinary team of researchers from the USI Institute of Computational Sciences (ICS), and the Institute for Research in Biomedicine (IRB), affiliated to USI, have developed a new Artificial Intelligence method that enables the analysis of complex biomedical data. The results of the research have been published in the renowned scientific journal Science advances .
Life Sciences - Computer Science - 14.10.2019
"Virtual microscopes" freely accessible, thanks to USI’s contribution
Molecular dynamics simulations represent an increasingly important cornerstone of modern scientific research, thanks to their unparalleled ability to meticulously describe fundamental aspects of complex systems. It is not a coincidence that nowadays molecular simulations are considered a "virtual microscope" from which admire and examine biological processes, as well as confirm through "computational assays" innovative hypotheses which provide the basis for designing new experiments.
Environment - Health - 07.10.2019
The impact of ambient air pollution on hospital admissions
Air pollution is the centre of debate on many fronts, from air protection measures involving road traffic, to technological innovations to reduce harmful emissions.
Physics - 19.09.2019
Quantum physics: beyond the logic of cause and effect
In classical, Newtonian theory, causality, the connection between cause and effect, is considered to sit at the core of physics: Causal thinking, together with the idea that absolute time and space are the pre-given stage for all physical events, have been dominating classical physics well into the twentieth century.
Pharmacology - Health - 10.09.2019

An international research team led by the Institute for Research in Biomedicine, affiliated to the Università della Svizzera italiana, has discovered why some patients with multiple sclerosis make an immune reaction that curtails the effectiveness of natalizumab, a therapeutic antibody used for the treatment of the disease and used this information to engineer a new version of the antibody that avoids this problem.
Pharmacology - Health - 05.08.2019
Future clinical studies in lymphoma patients
At the Institute of Oncology Research (IOR, affiliated to USI), researchers have discovered two molecules, so far known in the field of treatments against Ewing's sarcoma, which have strong antilymphoma activity, thus proposing clinical studies on patients. The study has been published in the scientific journal Clinical Cancer Research .
Social Sciences - Health - 17.06.2019
Social Exclusion Measured in fMRI
A fMRI study shows the effect of social support on the social exclusion experience. Social belonging is a fundamental need for the life of human beings.
Health - Life Sciences - 23.05.2019

Tumor stem cells from prostate cancer. The coloring with different fluorochromes highlights the extensive network of mitochondria (red/green) surrounding the cell nuclei (blue). A study by investigators at the Institute of Oncology Research (IOR, affiliated to USI Università della Svizzera italiana) reveals a new way to eliminate cancer stem cells (CSC) in prostate tumours and enhance treatment efficacy.
Astronomy & Space - Physics - 29.04.2019

Some of the CLASP-II scientists pose for a photograph in front of the rocket at White Sands Missile Range (New Mexico, USA) (image: U.S. Army, Louis Rosales) On April 11, 2019, at the NASA facility at the White Sands Missile Range in New Mexico (USA), the successful launch of a sounding rocket was performed as part of the "Chromospheric LAyer Spectro-Polarimeter" experiment (CLASP-II).
Administration - 25.03.2019

How do local tax havens emerge? Is tax competition harmful? Raphaël Parchet, Assistant professor at the Faculty of Economics of Università della Svizzera italiana, addresses these questions in his new project "Sorting, Tax Competition and the Rise of Local Tax Havens", funded by the Swiss National Science Foundation (SNSF), shedding new light on the logic behind the rise of tax havens in Switzerland.
Health - 08.03.2019

A collaborative project between the Institute for Research in Biomedicine (IRB, affiliated to USI) and several other European and American research institutes provides new hope for the development of an efficient vaccine against human Respiratory Syncytial Virus (hRSV), which is responsible, in particular, for acute lung infections such as bronchiolitis in children.
Computer Science - Mar 20
New computer chip material inspired by the human brain could slash AI energy use
New computer chip material inspired by the human brain could slash AI energy use

Politics - Mar 20
Argentina 50 years on from start of dictatorship - is it forgetting the disappeared?
Argentina 50 years on from start of dictatorship - is it forgetting the disappeared?
Life Sciences - Mar 20
Courting the Competition: Some Male Fruit Flies Serenade Each Other Rather Than Fight
Courting the Competition: Some Male Fruit Flies Serenade Each Other Rather Than Fight

Social Sciences - Mar 20
Louis Theroux's manosphere documentary shows some of the subtle ways we can undermine online misogyny
Louis Theroux's manosphere documentary shows some of the subtle ways we can undermine online misogyny

Life Sciences - Mar 20
Hidden Helpers: Pittsburgh's Industrial Past Might Hold the Key to a Cleaner Future
Hidden Helpers: Pittsburgh's Industrial Past Might Hold the Key to a Cleaner Future
Pharmacology - Mar 19
GSK, University of Oxford and Imperial College London launch centre to create computer models of lungs, liver, kidneys and cartilage
GSK, University of Oxford and Imperial College London launch centre to create computer models of lungs, liver, kidneys and cartilage

Innovation - Mar 19
India's new wave of Hindu Religious Entrepreneurship is reshaping our interpretation of success
India's new wave of Hindu Religious Entrepreneurship is reshaping our interpretation of success
Pharmacology - Mar 19
Oxford University spinout Dark Blue Therapeutics acquired to advance leukaemia treatment
Oxford University spinout Dark Blue Therapeutics acquired to advance leukaemia treatment
Veterinary - Mar 19
New RVC study challenges common beliefs on desirable behaviours in designer 'Doodle' crossbreeds
New RVC study challenges common beliefs on desirable behaviours in designer 'Doodle' crossbreeds

Agronomy & Food Science - Mar 19
Bird Flu Risk to Danish Cattle - New Tool Can Warn Farmers Before Infection Spreads
Bird Flu Risk to Danish Cattle - New Tool Can Warn Farmers Before Infection Spreads









